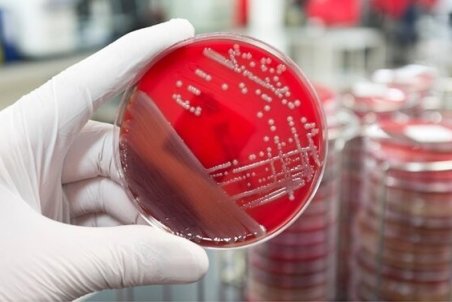
میکرو ارگانیسم های ساخت ایران برای نخستین بار صادر شد

ورود
اطلاعات بالا را برای ثبت نام تکمیل کنید
خبر خوش برای خودروسازان ایرانی
اقتصادنیوز : محققان دو شرکت دانشبنیان با ایجاد کنسرسیومی موفق به تولید سیستم عامل اختصاصی خودرو شدند و به گفته آنها کاربردی شدن آن امکان هر تغییری را به خودروسازان کشور میدهد.
1403/01/20 , 13:06
37
0
0
چالشهای تأمین مالی شرکتهای دانش بنیان / نقش بازار سرمایه چیست؟
دستورالعملی برای پذیرش شرکتهای دانشبنیان در حال تنظیم است که فعلاً در دست هیأت مدیره سازمان بورس قرار دارد. برای اینکه شرکتهای دانشبنیان در صف پذیرش شرکتهای عادی قرار نگیرند، دستورالعملی تصویب کردیم تا پذیرش شرکتهای دانشبنیان در بازار سرمایه تسهیل شود.
1402/06/7 , 18:45
141
0
0
توافق با گمرک برای ساخت آشکارسازهای کانتینری توسط دانش بنیانها
معاون علمی رئیس جمهور گفت: طی توافقی با گمرک قرار است دانش بنیان های ایرانی طی مدت ۲ سال ۵۰ دستگاه آشکارساز کانتینری را ساخته و تحویل گمرک دهند.
1402/05/21 , 21:18
85
0
0
تخصیص ۲۶ هزار میلیارد ریال تسهیلات به دانش بنیان های صنعت برق
دبیر ستاد اقتصاد دانش بنیان انرژی از تخصیص تسهیلات به شرکت های فعال در حوزه اصلاح الگوی مصرف انرژی در راستای اجرایی سازی آیین نامه حمایت از تولید، دانش بنیان در صنعت آب و برق خبر داد.
1402/05/21 , 12:30
69
0
0
رشد بی سابقه محصولات دانشبنیان در توسعه زیرساختهای ارتباطی
وزیر ارتباطات و فناوری اطلاعات گفت: در دو سال اخیر سهم محصولات شرکتهای دانشبنیان در توسعه زیرساختهای ارتباطی و فناوری اطلاعات کشور رشد بیسابقهای را تجربه کرده است
1402/05/17 , 14:35
94
0
0
جنگهای رسانهای و اقتصادی نوین را با کمک نخبگان پشت سر می گذاریم
سخنگوی دولت با اشاره به اینکه کشور ما موفق شده تحریم ها را پشت سربگذارد، گفت:در آینده نیز حتما با حمایت نخبگان، جنگ رسانه ای، جنگ های اقتصادی نوین و ترکیبی را حتما می توانیم پشت سر بگذریم.
1402/05/16 , 13:38
91
0
0
حمایت از طرحهای زیستی که به توسعه صنایع غذایی کمک میکنند/آخرین مهلت ارسال طرح
فناوران و صاحبان ایدهای که بتوانند با طرحهای خود مسیر توسعه صنایع غذایی را هموار کنند، برای تجاریسازی ایدههای خود حمایت میشوند.
1400/12/17 , 11:56
177
0
0
تخصیص تسهیلات اشتغالزایی قرضالحسنه به شرکتهای دانشبنیان
رئیس صندوق نوآوری و شکوفایی گفت: تسهیلات اشتغالزایی این صندوق در راستای افزایش اشتغال و کمک به توسعه شرکتهای دانش بنیان و به صورت قرضالحسنه به این شرکتها تخصیص مییابد.
1400/12/10 , 13:08
236
0
0
۵ شرکت سایپا دانش بنیان شدند
رییس اداره برنامه ریزی استراتژیک شرکتهای مالی و خدماتی گروه سایپا از حرکت این شرکتها به سمت دانش بنیان شدن خبر داد.
1400/12/9 , 09:14
149
0
0
ساخت دستگاه اکسیژنساز هوشمند با وزن ۲.۵ کیلوگرم
محققان دستگاه اکسیژن ساز با وزن ۲.۵ کیلوگرم را معرفی کردند که به صورت هوشمند و بر اساس نیاز بیمار اکسیژن مورد نیاز را تولید میکند.
1400/12/1 , 13:25
144
0
0
جرئیات اجرای طرح ملی استقرار کوتاهمدت شرکتهای دانشبنیان در پارکهای فناوری کشور
معاون فناوری و نوآوری وزیر علوم، تحقیقات و فناوری از تصویب و ابلاغ طرح ملی "استقرار کوتاهمدت واحدهای فناور و شرکتهای دانشبنیان در پارکهای علم و فناوری کشور" خبر داد و گفت: تصویب این طرح ملی در راستای اشتراک گذاری خدمات پارکهای علم و فناوری میان
1400/11/30 , 09:47
145
0
0
زیستبوم شرکتهای دانشبنیان و خلاق چگونه توسعه یافت
زیستبوم شرکتهای دانشبنیان و خلاق در کشور با ارائه خدماتی از سوی مرکز شرکتها و موسسات دانشبنیان معاونت علمی و فناوری ریاست جمهوری توسعه یافته، به طوری که امروز بیش از ۶ هزار و ۵۰۰ شرکت دانش بنیان و ۱۵۰۰ شرکت خلاق در کشور فعالیت میکنند.
1400/11/26 , 13:34
164
0
0
آغاز ثبتنام رویداد اینوتکس از امروز/شرایط بهرهمندی شرکتها از تخفیف ۳۰ تا ۷۰ درصدی
ثبت نام یازدهمین دوره رویداد اینوتکس پارک فناوری پردیس از امروز یکشنبه ۲۴ بهمن ماه آغاز شده است و شرکتهایی که تا ۱۴ اسفند نسبت به ثبت نام خود اقدام کنند، مشمول تخفیف ۳۰ درصدی خواهند شد.
1400/11/24 , 13:14
168
0
0
اعطای تسهیلات ودیعه رهن محل کار به دانشبنیانها با کارمزد ۴ درصد
معاون تسهیلات و تجاریسازی صندوق نوآوری و شکوفایی از پرداخت تسهیلات قرضالحسنه ودیعه رهن محل کار به شرکتهای دانشبنیان خارج از استان تهران خبرداد.
1400/11/23 , 10:34
148
0
0
شرکتهای پیشرو در داخلیسازی کالاهای وارداتی حمایت مالی میشوند
ایسنا/خراسان رضوی معاون وزیر صنعت، معدن و تجارت گفت: تولیدکنندگان بهویژه شرکتهای دانشبنیان که نسبت به افزایش داخلیسازی قطعات و کالاهای وارداتی پیشرو باشند، مورد حمایت به ویژه حمایت مالی قرار میگیرند.
1400/11/16 , 09:05
163
0
0
الزام سازمان برنامه و بودجه برای تامین مالی دانشبنیانهایی که تعهد کاری با دولتیها دارند
رئیس کمیته آموزش و تحقیقات کمیسیون آموزش مجلس شورای اسلامی گفت: بر اساس طرح جهش دانشبنیان، اگر شرکتهای دانشبنیان با دستگاههای اجرایی تعهد کاری داشته باشند، ولی دستگاهها قادر به اجرای تعهدات مالی بهموقع نباشند، سازمان برنامه و بودجه ملزم است از محل منابع
1400/11/14 , 17:56
166
0
0
توسعه محصولات دانشبنیان با ۳ خدمت تسهیل شد
برای حمایت از گسترش محصولات دانشبنیان و ترغیب بازار داخلی به خرید تولیدات ایرانساخت، سه خدمت "طراحی صنعتی محصولات دانشبنیان"، "طراحی و ساخت نمونه نمایشی(دمو) تولیدات" و "ارائه مشاوره توسعه فنی محصولات" در کشور ارائه میشود.
1400/11/13 , 12:59
178
0
0
خدمترسانی بیش از ۱۳۰ متخصص ایرانی خارج از کشور در زیستبوم نوآوری
امسال شرکتهای دانشبنیان از توانمندی تخصصی و دانشی بیش از 130 متخصص ایرانی خارج از کشور بهرهمند شدند.
1400/11/12 , 16:14
208
0
0
اضافه شدن ۳ هزار میلیارد تومان به سرمایه صندوق نوآوری/توسعه فناوری استانی و منطقهای میشود
معاون مرکز شرکتهای دانشبنیان معاونت علمی و فناوری ریاست جمهوری با بیان اینکه در قانون جهش تولید دانشبنیان، مبلغ ۳ هزار میلیارد تومان به سرمایه صندوق نوآوری و شکوفایی اضافه شده است، گفت: در این قانون همچنین مشوقهایی برای همکاری بخشهای صنعتی با شرکتهای
1400/11/12 , 06:29
267
0
0
حضور دانشبنیانها در نمایشگاه صنایع دریایی
دوازدهمین نمایشگاه بینالمللی صنایع دریایی و دریانوردی برگزار میشود.
1400/11/11 , 11:55
194
0
0
عرضه پلتفرمهای ارتباط با مشتریان از سوی دانشبنیانها
شرکتهای دانشبنیان به منظور توسعه کسبوکارها، پلتفرمهای تجارت الکترونیک و ارتباط با مشتریان را به بازار داخلی معرفی کردند.
1400/11/2 , 11:11
211
0
0
۷ محصول دانشبنیان در حوزه فناوریهای مکانمحور رونمایی میشود
نمایشگاه بینالمللی ایران ژئو، ۳۰ دیماه تا ۳ بهمنماه سال ۱۴۰۰ برگزار و در این نمایشگاه ضمن نمایش دستاوردها و توانمندیهای داخلی در حوزه ژئوماتیک از ۷ محصول دانشبنیان رونمایی میشود.
1400/10/28 , 16:27
184
0
0
اشتغال ۳ هزار متخصص در شرکتهای تاسیس شده توسط کارآفرینان ایرانی خارج از کشور
حمایت از بازگشت کارآفرینان ایرانی خارج از کشور و استفاده از ظرفیت آنها، آثار قابل توجهی در توسعه علمی کشور دارد و دانش و تخصص این افراد را به نیازهای داخلی پیوند میزند، به طوریکه تاکنون سه هزار متخصص در شرکتهای تاسیس شده توسط کارآفرینان ایرانی خارج از کشور
1400/10/26 , 18:57
193
0
0
تعاونیهای دانش بنیان؛ بستر اشتغال فارغ التحصیلان
کارشناسان بازار کار، تشکیل شرکتها و تعاونیهای دانش بنیان را از جمله راهکارهای موثر در اشتغال کارجویان و فارغ التحصیلان دانشگاهی و حمایت از ایدههای عملی نخبگان عنوان کرده و معتقدند:با توجه به آمار بالای فارغ التحصیلان بیکار، تشکیل شرکتهای دانش بنیان در قالب
1400/10/26 , 12:44
197
0
0
شرکتهای دانشبنیان به زمینه های بکر صنعت بیمه وارد شوند
رئیس کل بیمه مرکزی جمهوری اسلامی ایران با تاکید بر اینکه امروز صنعت بیمه از بیمه سلامت و شخص ثالث فراتر رفته است، گفت: با شیوع کرونا دنیا در زمینه استفاده از فناوری در این صنعت سرمایه گذاری کرده است که در ایران نیز زمینه های بکری وجود دارد که شرکت های دانش
1400/10/21 , 13:23
186
0
0
توسعه همکاری صنعت بیمه با دانشبنیانها برای رفع معضلات
سه قرارداد و دو تفاهم نامه بین شرکت های بیمه و دانشبنیان در صندوق نوآوری و شکوفایی به امضا رسید.
1400/10/21 , 12:34
251
0
0
آمادگی ۷۰ شرکت دانش بنیان برای رفع چالش های صنعت بیمه
معاون توسعه صندوق نوآوری و شکوفایی با بیان اینکه با همکاری بیمه مرکزی نیازمندی های صنعت بیمه استخراج شد، گفت: با اعلام فراخوان، ۷۰ شرکت آمادگی خود را برای رفع چالش های این صنعت اعلام کردند.
1400/10/21 , 12:28
242
0
0
حمایت ۷۰ درصدی صندوق نوآوری از دانشبنیانها برای عضویت در اتاق بازرگانی
رییس مرکز نوآوری اتاق بازرگانی تهران از توافق این اتاق با صندوق نوآوری و شکوفایی برای عضویت شرکتهای دانشبنیان در اتاق بازرگانی تهران خبر داد.
1400/10/11 , 15:28
372
0
0
شرکتهای نوپای دانشبنیان با اصول مالیاتی و مالی آشنا میشوند
برای شرکتهای نوپای دانش بنیان دوره آشنایی با اصول و قوانین مالی شرکتها برگزار میشود.
1400/10/11 , 10:30
184
0
0
شناخت نیازهای بازار و ارتقای گفتمان مهارت آموزی
با راه اندازی شبکه پژوهش مهارت، زمینه ارتقای گفتمان مهارت آموزی از طریق یافتههای پژوهشی، دسترسی به گروه شنخبگان مهارتی و ترویج فرهنگ پژوهش و مهارت آموزی فراهم می شود.
1400/10/6 , 15:38
211
0
0
شرکتهای دانشبنیان ساخت "آنزیم"های کیتهای تشخیص کرونا را آغاز کردهاند
مدیر کل توسعه فناوری سلامت وزارت بهداشت درباره تهیه کیتهای تشخیصی pcr در ایران گفت: در زمینه دانش تولید تستهای تشخیصی pcr کرونا اصلا مشکلی نداریم. حجم تولید این کیتها بسته به نیاز بازار ممکن است کم یا زیاد شود. در عین حال بخشی از آنزیمهای قابل استفاده در
1399/06/28 , 17:08
268
0
0
الزام دستگاه های اجرایی بر استفاده از ظرفیت شرکت های دانش بنیان در توسعه خدمات الکترونیک
معاون استاندار قم در جریان بازدید از دستگاه های اجرایی استان و با اشاره به خدمات ملی شرکت های بومی دانش بنیان استان در عرصه خدمات الکترونیک، بر استفاده دستگاههای اجرایی استان از این ظرفیت تاکید کرد.
1399/02/8 , 14:26
276
0
0
دانش بنیانها ۱۰۰ میلیارد تومان تفاهمنامه در صنعت آب منعقد کردند
رییس ستاد خشکسالی، فرسایش و محیط زیست معاونت علمی ریاست جمهوری گفت: در این رویداد تا کنون ۲۶ تفاهمنامه به ارزش ۱۰۰ میلیارد تومان در صنعت آب به امضا رسیده است.
1398/09/10 , 16:31
361
0
0
بهرهمندی ۱۵ استان کشور از نانو محلول ضدعفونیکننده دام و طیور
یکی از شرکتهای دانشبنیان به دانش فنی تولید ضد عفونیکنندههای نانویی با کاربرد در صنایع طیور و دام دست یافته و با توزیع ۲۵ هزار لیتر مایع از این ضدعفونیکنندهها موجب کاهش میزان مرگومیر دام و طیور شده است.
1398/08/21 , 16:39
490
0
0
معرفی ۲ هزار شرکت دانشبنیان برای برخورداری از معافیت مالیاتی
مشاور معاون علمی رئیس جمهور از معرفی ۲ هزار شرکت دانشبنیان برای برخورداری از معافیت مالیاتی خبر دارد.
1398/08/1 , 15:31
557
0
0
شرکتهای دانشبنیان برای رونق صنعت واکسن به میدان بیایند
دبیر ستاد توسعه زیستفناوری معاونت علمی و فناوری ریاست جمهوری، گفت: شرکتهای دانش بنیان می توانند نقش مهمی در ذخیره سازی نیروی انسانی مورد نیاز صنایع مختلف به ویژه صنعت واکسن داشته باشند.
1398/07/14 , 16:31
440
0
0
میکرو ارگانیسم های ساخت ایران برای نخستین بار صادر شد
یک شرکت دانش بنیان که اولین و تنها تولیدکننده مکملهای غذایی تولید شده از میکروارگانیسمهای مفید است، موفق شد برای اولین بار این محصولات را به چند کشور صادر کند.
1398/07/6 , 17:09
422
0
0
برترینهای آزمون استخدامی شرکتهای دانشبنیان مشمول تسهیلات سربازی میشوند
مدیر شبکه نوآوری پارک فناوری پردیس با بیان اینکه تاکنون به ۱۵۰۰ شرکت خدمات ارائه کردهایم، گفت: این شبکه در زمینه ارائه تسهیلات به برگزیدههای آزمون استخدامی شرکتهای فناور برنامه دارد.
1398/07/6 , 17:05
391
0
0
بیش از ۴هزار شرکت دانشبنیان در اقتصاد کشور نقشآفرین شدند
با اجرایی شدن قانون حمایت از شرکتهای دانشبنیان، اکنون ۴۴۶۲ شرکت از این حمایتها بهرهمند شدهاند. این شرکتها بیش از ۳۰۰ هزار شغل ایجاد کرده و فروشی بیش از ۹۰۰ هزار میلیارد ریال در سال به ارمغان آوردهاند.
1398/06/10 , 15:33
421
0
0
کاهش خوردگی تانکرها و خطوط ریلی با نانوپوششهای دوستدار محیطزیست
محققان یکی از شرکتهای دانشبنیان با استفاده از فناوری نانو، پوششهایی را توسعه دادند که علاوه بر آنکه کاربرد آن موجب ارتقای عملکرد پابندهای خطوط ریلی شد، از آن برای کاهش میزان خوردگی تانکرها استفاده شده است.
1398/06/6 , 15:36
401
0
0
ارائه خدمات تعمیر و ساخت قطعات هواپیمای بومی به ۱۱ ایرلاین
یکی از شرکتهای دانشبنیان فعال در زمینه تعمیر و نگهداری هواپیما با اخذ گواهینامههای مرتبط توانسته است خدمات خود را به ۱۱ ایرلاین ارائه دهد.
1398/05/17 , 16:05
437
0
0
صادرات نانوپلیمر سیلیکون ایرانی به کشورهای همسایه
نانومحصولات پلیمری یک شرکت دانشبنیان بعد از صادرات به کشور عراق راهی کشور ترکیه میشود.
1398/05/9 , 16:20
489
0
0
پرههای توربین ساخت داخل در خدمت صنعت نیروگاهی
یکی از شرکتهای دانشبنیان داخلی توانسته است یکی از نیازهای اساسی صنعت نیروگاهی کشور را با فناوری بومی تولید کند.
1398/05/8 , 15:36
482
0
0
ردیابی گونههای دریایی در خطر انقراض با کمک شرکتهای دانش بنیان
مدیر کل دفتر زیست بومهای دریایی سازمان حفاظت محیط زیست گفت: در زمینه پایش زیستبومهای دریایی، با شرکتهای دانش بنیان فعال در زمینه هوافضا مذاکراتی انجام شده تا گونههای دریایی در معرض خطر انقراض و تغییرات زیستگاههای ساحلی را پایش و ردیابی کنیم.
1398/05/5 , 15:54
441
0
0
زمینه بخشودگی بدهی شرکتهای دانشبنیان به تامین اجتماعی فراهم شد
رئیس کارگروه تشخیص صلاحیت شرکتهای دانش بنیان گفت: طی فرآیندی زمینه بخشودگی جرایم شرکتهای دانشبنیانی که تا پایان ۹۶ به تامین اجتماعی بدهی دارند، فراهم شده است.
1398/04/30 , 15:55
495
0
0
پاویون محصولات دارویی ایرانی در نمایشگاه آلمان برپا می شود
پاویون ملی محصولات دانشبنیان صادراتی ایران در نمایشگاه دارویی آلمان برپا میشود.
1398/04/26 , 16:22
638
0
0
نیاز مالی نباید مانع فعالیتهای دانشبنیان شود
رئیس صندوق نوآوری و شکوفایی با تاکید بر اینکه برای حمایت از شرکتهای دانشبنیان محدودیت مالی وجود ندارد، گفت: تاکید ما براین است که مسائل مالی، مانع فعالیت هیچ شرکت دانشبنیانی نشود.
1398/04/16 , 15:35
469
0
0
تولید اسپری های ضد عفونی کننده هوا توسط محققان کشور
محققان یک شرکت دانش بنیان موفق به تولید اسپری هایی شدند که فضای یک محیط را عاری از هر گونه باکتری می کند.
1398/04/12 , 16:14
470
0
0